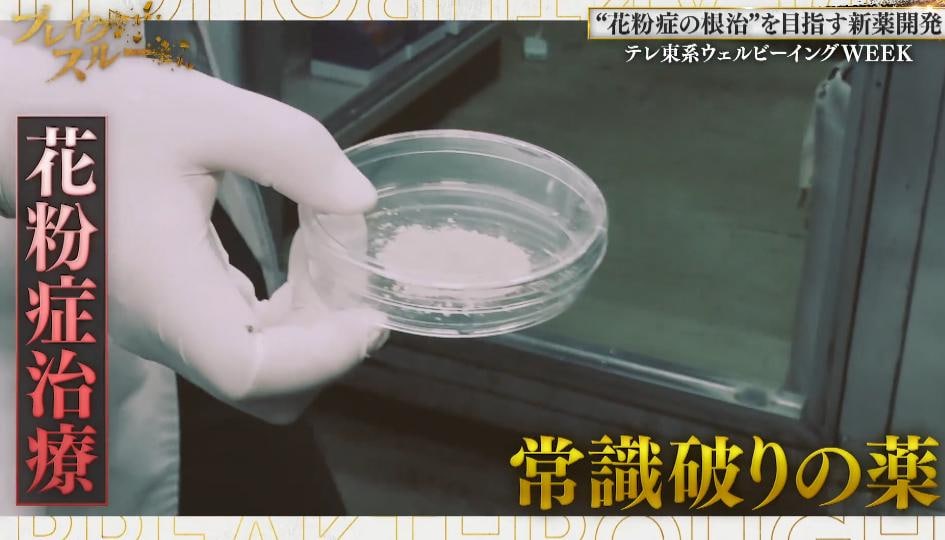
記事画像

“花粉症の根治”を目指す新薬開発…食物アレルギーや喘息も!?
更新日:
 イチオシスト
イチオシスト
ライター / 編集
イチオシ編集部 旬ニュース担当
注目の旬ニュースを編集部員が発信!「イチオシ」は株式会社オールアバウトが株式会社NTTドコモと共同で開設したレコメンドサイト。毎日トレンド情報をお届けしています。
3月14日(土)に放送した「ブレイクスルー」(毎週土曜 午前10時30分)を、「TVer」「ネットもテレ東」「テレ東BIZ」で無料配信中!
※「TVer」「ネットもテレ東」は期間限定無料配信、「テレ東BIZ」は無期限有料配信。
【動画】“花粉症の根治”を目指す新薬開発…食物アレルギーや喘息も!?
日本人の2人に1人が抱える悩み「花粉症」。花粉症のシーズンには、労働力の低下による経済損失が、1日2450億円にもなるとの試算もある。

そんな悩みから人類を解放しようと立ち上がったのが、山梨大学大学院の中村勇規准教授だ。花粉症と深く関わっている「マスト細胞」を除去することで、花粉症の根治を目指す薬の開発に取り組んでいる。
さらに、マスト細胞に関係する、食物アレルギーや喘息の改善にも挑んでいた。
アレルギーの苦しみから生活と命を守ろうと奮闘する開拓者に、作家・相場英雄が迫る!
出演:相場英雄(作家)、佐々木明子(テレビ東京アナウンサー)
開拓者:山梨大学大学院 総合研究部 中村勇規 准教授
ナレーター:谷田歩(俳優)
3月21日(土)は、「日本流!フィジカルAI歩行ロボ」を放送。
記事提供元:テレ東プラス
※記事内容は執筆時点のものです。最新の内容をご確認ください。
